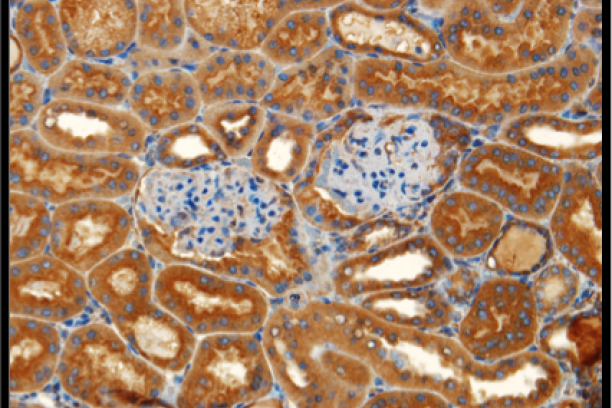

The focus of Dr Vanacore’s research is aimed at the study of basement membrane proteins, particularly collagen IV and its modifying enzymes, which are involved in human diseases such as diabetic nephropathy, vascular disease, Goodpasture disease, and Alport syndrome. Collagen IV forms crosslinked supramolecular scaffolds that are essential for the mechanical stability of basement membranes and act as ligand for integrins influencing cell behaviors such as proliferation, differentiation, and migration. Dr. Vanacore has made important discoveries about the chemistry and pathology of basement membranes, including the discovery and assembly mechanism of the novel evolutionary conserved sulfilimine bond (S=N) that crosslinks the carboxyl-terminal NC1 domain of collagen IV, the first of its kind in a biomolecule. More recently, Dr Vanacore is investigating the role of the crosslinking enzyme lysyl oxidase on the stabilization of collagen IV network structure. These investigations pursue a better understanding of this enzyme in normal tissue function and development as well as in pathological states, including renal fibrosis and tumorigenesis. For our investigations we use state-of-the-art mass spectrometry-based proteomics and bioinformatics tools in addition to a variety of biochemical molecular and cell biology techniques.
Research
Structural, Chemical and Functional Studies of Basement Membranes in Health and Disease
-
Summer 2015 -

Crystal structure of the NC1 hexamer of collagen IV. Novel sulfilimine bonds (green) crosslink the interaction between triple-helical protomers. -
Immunohistochemical detection of lysyl oxidases in renal cortex -

Immunofluorescent detection of collagen IV in extracellular matrix produced by cultured cells -

Collagen IV NC1 hexamers -

Summer 2016 -

Summer 2017